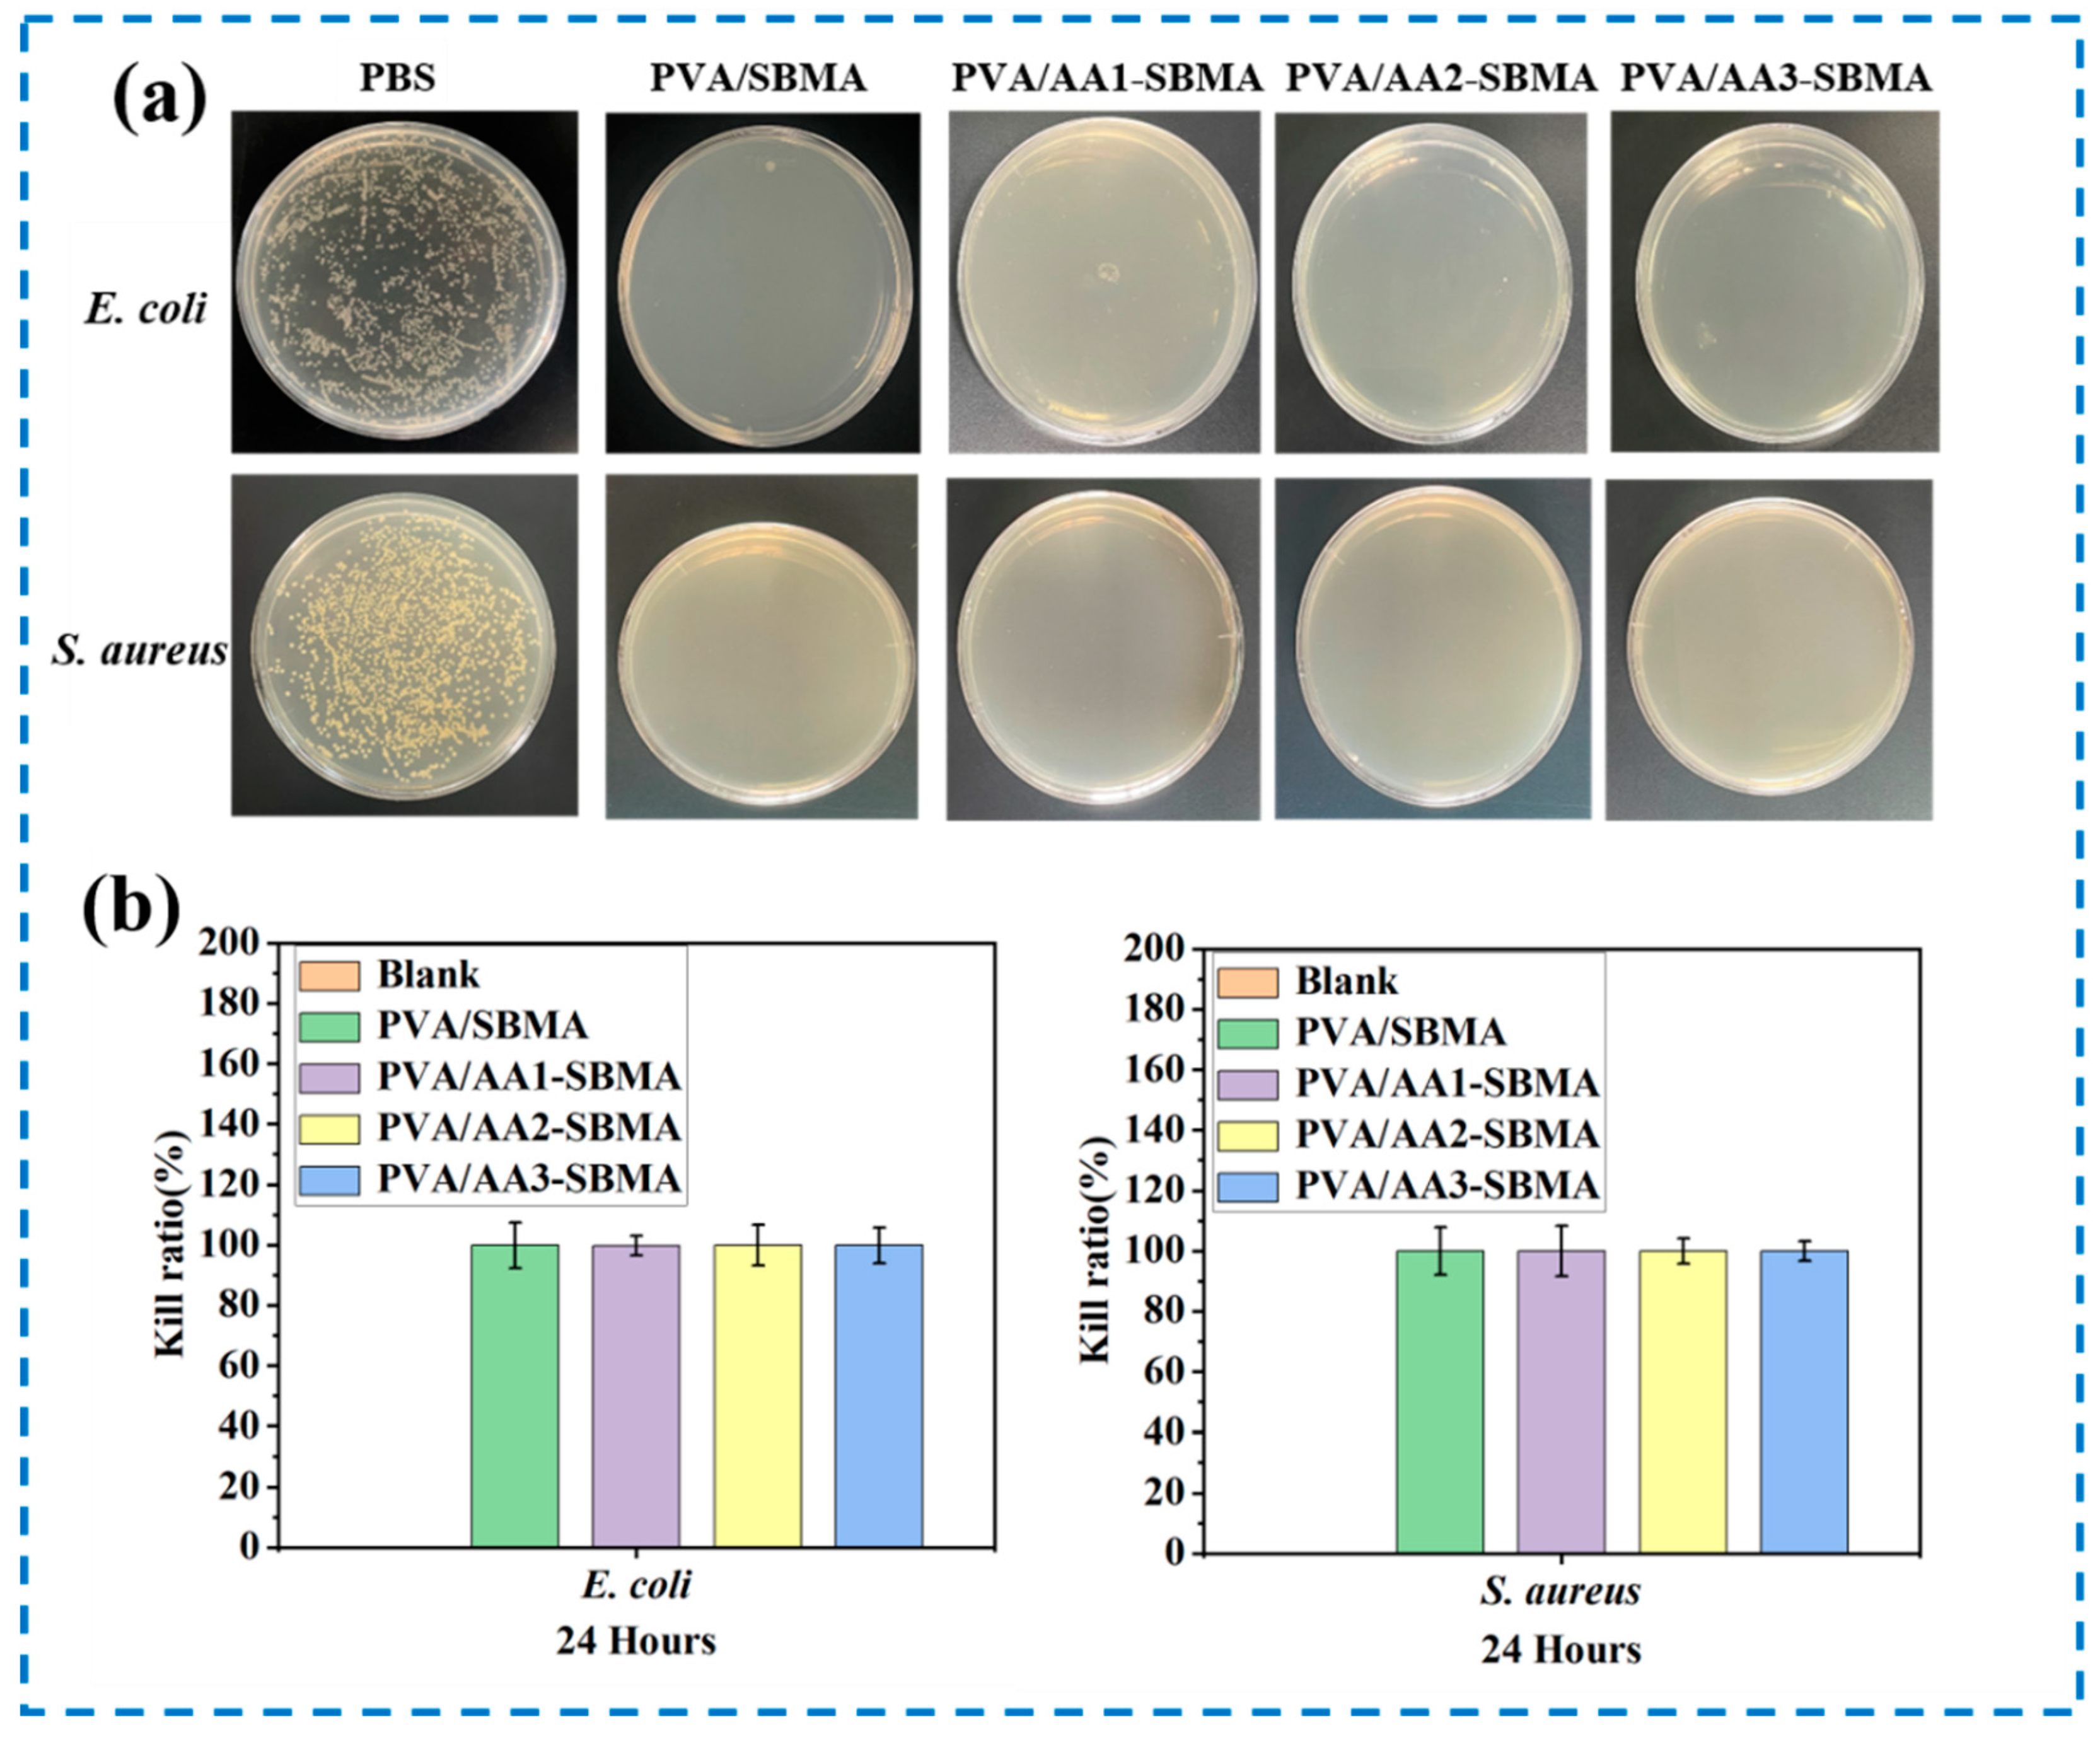
Polymers 17 02230 g005

Anti-Swelling Dual-Network Zwitterionic Conductive Hydrogels for Flexible Human Activity Sensing
Abstract
1. Introduction
2. Experimental Section
3. Results and Discussion
3.1. Preparation of Hydrogels
3.2. Characterization of Hydrogels
3.3. The Mechanical Properties of Hydrogels
3.4. The Anti-Swelling Properties of Hydrogels
3.5. Antibacterial Activities of Hydrogels
3.6. Biocompatibility of Hydrogels
3.7. The Sensing Properties of Hydrogels
4. Conclusions
Supplementary Materials
Author Contributions
Funding
Data Availability Statement
Acknowledgments
Conflicts of Interest
References
- Devi, L.S.; Palathinkal, R.P.; Dasmahapatra, A.K. Preparation of cross-linked PANI/PVA conductive hydrogels for electrochemical energy storage and sensing applications. Polymer 2024, 293, 126673. [Google Scholar] [CrossRef]
- Liang, L.; Liang, X.; Lin, X.; Zhang, H.; Pang, C.; Pan, X.; Hu, Y.; Chen, Y.; Luo, X. Construction mechanism of gellan gum/chitosan/calcium ion multiple-network hydrogel by self-assembly strategy and its regulation. Polym. Eng. Sci. 2023, 64, 689–705. [Google Scholar] [CrossRef]
- Wang, X.; Wang, G.; Liu, W.; Yu, D.; Liu, X.; Li, G.; Song, Z.; Wang, H. Developing a carbon composite hydrogel with a highly conductive network to improve strain sensing performance. Carbon 2024, 216, 118500. [Google Scholar] [CrossRef]
- Ling, Q.; Fan, X.; Ling, M.; Liu, J.; Zhao, L.; Gu, H. Collagen-Based Organohydrogel Strain Sensor with Self-Healing and Adhesive Properties for Detecting Human Motion. ACS Appl. Mater. Interfaces 2023, 15, 12350–12362. [Google Scholar] [CrossRef] [PubMed]
- Gao, C.; Zheng, D.; Long, B.; Chen, Z.; Zhu, J.; Gao, Q. Anti-swelling and adhesive γ-PGA/PVA/PEDOT:PSS/TA composite conductive hydrogels for underwater wearable sensors. Eur. Polym. J. 2023, 201, 112590. [Google Scholar] [CrossRef]
- Ying, B.; Chen, R.Z.; Zuo, R.; Li, J.; Liu, X. An Anti-Freezing, Ambient-Stable and Highly Stretchable Ionic Skin with Strong Surface Adhesion for Wearable Sensing and Soft Robotics. Adv. Funct. Mater. 2021, 31, 2104665. [Google Scholar] [CrossRef]
- Liu, Z.; Wang, Y.; Ren, Y.; Jin, G.; Zhang, C.; Chen, W.; Yan, F. Poly(ionic liquid) hydrogel-based anti-freezing ionic skin for a soft robotic gripper. Mater. Horiz. 2020, 7, 919–927. [Google Scholar] [CrossRef]
- Xu, M.; Liao, J.; Li, J.; Shi, Y.; Zhang, Z.; Fu, Y.; Gu, Z.; Xu, H. Elastic Nanoparticle-Reinforced, Conductive Structural Color Hydrogel With Super Stretchability, Self-Adhesion, Self-Healing as Electrical/Optical Dual-Responsive Visual Electronic Skins. Exploration 2025, 5, 270008. [Google Scholar] [CrossRef]
- Guo, M.; Yang, X.; Yan, J.; An, Z.; Wang, L.; Wu, Y.; Zhao, C.; Xiang, D.; Li, H.; Li, Z.; et al. Anti-freezing, conductive and shape memory ionic glycerol-hydrogels with synchronous sensing and actuating properties for soft robotics. J. Mater. Chem. A 2022, 10, 16095–16105. [Google Scholar] [CrossRef]
- Zhao, Y.; Ohm, Y.; Liao, J.; Luo, Y.; Cheng, H.-Y.; Won, P.; Roberts, P.; Carneiro, M.R.; Islam, M.F.; Ahn, J.H.; et al. A self-healing electrically conductive organogel composite. Nat. Electron. 2023, 6, 206–215. [Google Scholar] [CrossRef]
- Song, H.; Wang, Y.; Fei, Q.; Nguyen, D.H.; Zhang, C.; Liu, T. Cryopolymerization-enabled self-wrinkled polyaniline-based hydrogels for highly stretchable all-in-one supercapacitors. Exploration 2022, 2, 20220006. [Google Scholar] [CrossRef]
- Li, Y.; Cheng, Q.; Deng, Z.; Zhang, T.; Luo, M.; Huang, X.; Wang, Y.; Wang, W.; Zhao, X. Recent Progress of Anti-Freezing, Anti-Drying, and Anti-Swelling Conductive Hydrogels and Their Applications. Polymers 2024, 16, 971. [Google Scholar] [CrossRef] [PubMed]
- Sun, Z.; Ou, Q.; Dong, C.; Zhou, J.; Hu, H.; Li, C.; Huang, Z. Conducting polymer hydrogels based on supramolecular strategies for wearable sensors. Exploration 2024, 4, 20220167. [Google Scholar] [CrossRef] [PubMed]
- Zhan, Y.; Fu, W.; Xing, Y.; Ma, X.; Chen, C. Advances in versatile anti-swelling polymer hydrogels. Mater. Sci. Eng. 2021, 127, 112208. [Google Scholar] [CrossRef] [PubMed]
- Wang, S.; Liu, J.; Wang, L.; Cai, H.; Wang, Q.; Wang, W.; Shao, J.; Dong, X. Underwater Adhesion and Anti-Swelling Hydrogels. Adv. Mater. Technol. 2022, 8, 2201477. [Google Scholar] [CrossRef]
- Chen, K.; Liang, K.; Liu, H.; Liu, R.; Liu, Y.; Zeng, S.; Tian, Y. Skin-Inspired Ultra-Tough Supramolecular Multifunctional Hydrogel Electronic Skin for Human-Machine Interaction. Nano-Micro Lett. 2023, 15, 102. [Google Scholar] [CrossRef]
- Li, B.; Kan, L.; Li, C.; Li, W.; Zhang, Y.; Li, R.; Wei, H.; Zhang, X.; Ma, N. Adaptable ionic liquid-containing supramolecular hydrogel with multiple sensations at subzero temperatures. J. Mater. Chem. C 2021, 9, 1044–1050. [Google Scholar] [CrossRef]
- Wei, J.; Xiao, P.; Chen, T. Water-Resistant Conductive Gels toward Underwater Wearable Sensing. Adv. Mater. 2023, 35, e2211758. [Google Scholar] [CrossRef]
- Zhao, Z.; Qin, X.; Cao, L.; Li, J.; Wei, Y. Chitosan-enhanced nonswelling hydrogel with stable mechanical properties for long-lasting underwater sensing. Int. J. Biol. Macromol. 2022, 212, 123–133. [Google Scholar] [CrossRef]
- Huang, H.; Shen, J.; Wan, S.; Han, L.; Dou, G.; Sun, L. Wet-Adhesive Multifunctional Hydrogel with Anti-swelling and a Skin-Seamless Interface for Underwater Electrophysiological Monitoring and Communication. ACS Appl. Mater. Interfaces 2023, 15, 11549–11562. [Google Scholar] [CrossRef]
- Di, X.; Hou, J.; Yang, M.; Wu, G.; Sun, P. A bio-inspired, ultra-tough, high-sensitivity, and anti-swelling conductive hydrogel strain sensor for motion detection and information transmission. Mater. Horiz. 2022, 9, 3057–3069. [Google Scholar] [CrossRef] [PubMed]
- Qi, C.; Dong, Z.; Huang, Y.; Xu, J.; Lei, C. Tough, Anti-Swelling Supramolecular Hydrogels Mediated by Surfactant-Polymer Interactions for Underwater Sensors. ACS Appl. Mater. Interfaces 2022, 14, 30385–30397. [Google Scholar] [CrossRef]
- Wei, J.; Zheng, Y.; Chen, T. A fully hydrophobic ionogel enables highly efficient wearable underwater sensors and communicators. Mater. Horiz. 2021, 8, 2761–2770. [Google Scholar] [CrossRef]
- Gao, Y.; Wang, Y.; Dai, Y.; Wang, Q.; Xiang, P.; Li, Y.; Gao, G. Amylopectin based hydrogel strain sensor with good biocompatibility, high toughness and stable anti-swelling in multiple liquid media. Eur. Polym. J. 2022, 164, 110981. [Google Scholar] [CrossRef]
- Zou, C.Y.; Lei, X.X.; Hu, J.J.; Jiang, Y.L.; Li, Q.J.; Song, Y.T.; Zhang, Q.Y.; Li-Ling, J.; Xie, H.Q. Multi-crosslinking hydrogels with robust bio-adhesion and pro-coagulant activity for first-aid hemostasis and infected wound healing. Bioact. Mater. 2022, 16, 388–402. [Google Scholar] [CrossRef]
- Peng, X.; Liu, H.; Yin, Q.; Wu, J.; Chen, P.; Zhang, G.; Liu, G.; Wu, C.; Xie, Y. A zwitterionic gel electrolyte for efficient solid-state supercapacitors. Nat. Commun. 2016, 7, 11782. [Google Scholar] [CrossRef]
- Lu, Q.; Wang, Z.; Zhang, S.; Wang, J.; Mao, X.; Xie, L.; Liu, Q.; Zeng, H. Molecular interaction mechanism for humic acids fouling resistance on charged, zwitterion-like and zwitterionic surfaces. J. Colloid Interface Sci. 2024, 666, 393–402. [Google Scholar] [CrossRef] [PubMed]
- Lei, T.; Duan, X.; Zhao, H.; Ma, S.; Ma, X.; Wang, N.; Zhang, Q.; Wan, A.; Xia, Z.; Shou, W.; et al. A multifunctional flexible wearable hydrogel sensor with anti-swelling via supramolecular interactions for underwater motion detection and information transmission. Chem. Eng. J. 2025, 504, 158700. [Google Scholar] [CrossRef]
- Li, W.; Chen, W.; Ma, L.; Yang, J.; Gao, M.; Wang, K.; Yu, H.; Lv, R.; Fu, M. Robust double-network polyvinyl alcohol-polypyrrole hydrogels as high-performance electrodes for flexible supercapacitors. J. Colloid Interface Sci. 2023, 652, 540–548. [Google Scholar] [CrossRef] [PubMed]
- Hu, L.; Wang, Y.; Liu, Q.; Liu, M.; Yang, F.; Wang, C.; Pan, P.; Wang, L.; Chen, L.; Chen, J. Real-time monitoring flexible hydrogels based on dual physically cross-linked network for promoting wound healing. Chin. Chem. Lett. 2023, 34, 108262. [Google Scholar] [CrossRef]
- Jin, X.; Wei, C.; Wu, C.; Zhang, W. Gastric fluid-induced double network hydrogel with high swelling ratio and long-term mechanical stability. Compos. Part B Eng. 2022, 236, 109816. [Google Scholar] [CrossRef]
- Deng, Z.; Guo, Y.; Wang, X.; Song, J.; Yang, G.; Shen, L.; Wang, Y.; Zhao, X.; Guo, B.; Wang, W. Multiple crosslinked, self-healing, and shape-adaptable hydrogel laden with pain-relieving chitosan@borneol nanoparticles for infected burn wound healing. Theranostics 2025, 15, 1439–1455. [Google Scholar] [CrossRef]
- Wu, Y.; Zhou, S.; Yi, J.; Wang, D.; Wu, W. Facile fabrication of flexible alginate/polyaniline/graphene hydrogel fibers for strain sensor. J. Eng. Fibers Fabr. 2022, 17, 2107404. [Google Scholar] [CrossRef]
- Gao, Y.; Zhang, Z.; Ren, X.; Jia, F.; Gao, G. A hydrogel sensor driven by sodium carboxymethyl starch with synergistic enhancement of toughness and conductivity. J. Mater. Chem. B 2022, 10, 5743–5752. [Google Scholar] [CrossRef] [PubMed]
- Zheng, Z.; Xu, W.; Wang, Y.; Xiong, W.; Xiong, C.; You, L.; Wang, S. High-conductivity and long-term stability strain sensor based on silk fibroin and polyvinyl alcohol hydrogels. Mater. Today Commun. 2024, 38, 108465. [Google Scholar] [CrossRef]
- Zhang, Y.; Li, J.; Yu, X.; Han, D.; Xu, Y. Micro-corrugated chiral nematic cellulose nanocrystal films integrated with ionic conductive hydrogels leads to flexible materials for multidirectional strain sensing applications. Int. J. Biol. Macromol. 2025, 295, 139569. [Google Scholar] [CrossRef]
- Guo, P.; Liang, J.; Li, Y.; Lu, X.; Fu, H.; Jing, H.; Guan, S.; Han, D.; Niu, L. High-strength and pH-responsive self-healing polyvinyl alcohol/poly 6-acrylamidohexanoic acid hydrogel based on dual physically cross-linked network. Colloids Surf. A Physicochem. Eng. Asp. 2019, 571, 64–71. [Google Scholar] [CrossRef]
- Min, H.J.; Park, M.S.; Kang, M.; Kim, J.H. Excellent film-forming, ion-conductive, zwitterionic graft copolymer electrolytes for solid-state supercapacitors. Chem. Eng. J. 2021, 412, 127500. [Google Scholar] [CrossRef]
- Wu, J.; Xiao, Z.; Chen, A.; He, H.; He, C.; Shuai, X.; Li, X.; Chen, S.; Zhang, Y.; Ren, B.; et al. Sulfated zwitterionic poly(sulfobetaine methacrylate) hydrogels promote complete skin regeneration. Acta Biomater. 2018, 71, 293–305. [Google Scholar] [CrossRef]
- Liang, J.; Xu, J.; Zheng, J.; Zhou, L.; Yang, W.; Liu, E.; Zhu, Y.; Zhou, Q.; Liu, Y.; Wang, R.; et al. Bioinspired Mechanically Robust and Recyclable Hydrogel Microfibers Based on Hydrogen-Bond Nanoclusters. Adv. Sci. 2024, 11, 2401278. [Google Scholar] [CrossRef]
- Dong, X.; Guo, X.; Liu, Q.; Zhao, Y.; Qi, H.; Zhai, W. Strong and Tough Conductive Organo-Hydrogels via Freeze-Casting Assisted Solution Substitution. Adv. Funct. Mater. 2022, 32, 2203610. [Google Scholar] [CrossRef]
- Chang, L.; Kong, B.; Liu, Q.; Du, X.; Xia, X. Effect of freeze-thaw processes on the water-absorption ability and mechanical properties of hydrogel pads with chitosan/poly(vinyl alcohol) based on citrate crosslinks. Food Chem. 2025, 471, 142785. [Google Scholar] [CrossRef]
- Ren, J.; Liu, Y.; Wang, Z.; Chen, S.; Ma, Y.; Wei, H.; Lü, S. An Anti-Swellable Hydrogel Strain Sensor for Underwater Motion Detection. Adv. Funct. Mater. 2021, 32, 2107404. [Google Scholar] [CrossRef]
- Liu, D.; Cao, Y.; Jiang, P.; Wang, Y.; Lu, Y.; Ji, Z.; Wang, X.; Liu, W. Tough, Transparent, and Slippery PVA Hydrogel Led by Syneresis. Small 2023, 19, e2206819. [Google Scholar] [CrossRef] [PubMed]
- Ma, Y.; Dong, Q. Soybean Protein Isolate-Incorporated Zwitterionic Hydrogel with Rapid Chlorine Rechargeable Biocidal and Antifouling Functions. ACS Sustain. Chem. Eng. 2023, 11, 12843–12852. [Google Scholar] [CrossRef]
- Gratzl, G.; Walkner, S.; Hild, S.; Hassel, A.W.; Weber, H.K.; Paulik, C. Mechanistic approaches on the antibacterial activity of poly(acrylic acid) copolymers. Colloids Surf. B Biointerfaces 2015, 126, 98–105. [Google Scholar] [CrossRef] [PubMed]
- Gao, X.; Wang, Y.; Wu, J.; Xue, Z.; Yan, C.; Zhang, H.; Wang, Y.; Zhang, Y.; Jiang, M.; Zhao, Y. Lignin-Ethylene Glycol Improved Hydrogel with Antifreezing and Antiswelling Properties As a Flexible Sensor for Underwater Motion Monitoring. ACS Sustain. Chem. Eng. 2024, 12, 15159–15172. [Google Scholar] [CrossRef]
- Ling, Q.; Liu, W.; Liu, J.; Zhao, L.; Ren, Z.; Gu, H. Highly Sensitive and Robust Polysaccharide-Based Composite Hydrogel Sensor Integrated with Underwater Repeatable Self-Adhesion and Rapid Self-Healing for Human Motion Detection. ACS Appl. Mater. Interfaces 2022, 14, 24741–24754. [Google Scholar] [CrossRef]
- Li, X.; He, R.; Liu, X.; Blennow, A.; Ye, Q.; Hong, B.; Li, X.; Lu, L.; Cui, B. “Soaking-in-water” strategy stimulated starch/poly(vinyl alcohol)-based flexible hydrogel with heterogeneous network for highly sensitive underwater wearable sensor. Sustain. Mater. Technol. 2024, 41, e01049. [Google Scholar] [CrossRef]
- Jiang, H.; Hao, Z.; Zhang, J.; Tang, J.; Li, H. Bioinspired swelling enhanced hydrogels for underwater sensing. Colloids Surf. A 2023, 664, 131197. [Google Scholar] [CrossRef]

| Designation | PVA | AA | SBMA |
|---|---|---|---|
| PVA/SBMA | 1.0 g | / | 1.2 g |
| PVA/AA1-SBMA | 1.0 g | 2.0 mL | 1.2 g |
| PVA/AA2-SBMA | 1.0 g | 3.0 mL | 1.2 g |
| PVA/AA3-SBMA | 1.0 g | 4.0 mL | 1.2 g |
Disclaimer/Publisher’s Note: The statements, opinions and data contained in all publications are solely those of the individual author(s) and contributor(s) and not of MDPI and/or the editor(s). MDPI and/or the editor(s) disclaim responsibility for any injury to people or property resulting from any ideas, methods, instructions or products referred to in the content. |
© 2025 by the authors. Licensee MDPI, Basel, Switzerland. This article is an open access article distributed under the terms and conditions of the Creative Commons Attribution (CC BY) license (https://creativecommons.org/licenses/by/4.0/).
Share and Cite
Deng, Z.; Shen, L.; Cheng, Q.; Li, Y.; Liu, Q.; Zhao, X. Anti-Swelling Dual-Network Zwitterionic Conductive Hydrogels for Flexible Human Activity Sensing. Polymers 2025, 17, 2230. https://doi.org/10.3390/polym17162230
Deng Z, Shen L, Cheng Q, Li Y, Liu Q, Zhao X. Anti-Swelling Dual-Network Zwitterionic Conductive Hydrogels for Flexible Human Activity Sensing. Polymers. 2025; 17(16):2230. https://doi.org/10.3390/polym17162230
Chicago/Turabian StyleDeng, Zexing, Litong Shen, Qiwei Cheng, Ying Li, Qianqian Liu, and Xin Zhao. 2025. "Anti-Swelling Dual-Network Zwitterionic Conductive Hydrogels for Flexible Human Activity Sensing" Polymers 17, no. 16: 2230. https://doi.org/10.3390/polym17162230
APA StyleDeng, Z., Shen, L., Cheng, Q., Li, Y., Liu, Q., & Zhao, X. (2025). Anti-Swelling Dual-Network Zwitterionic Conductive Hydrogels for Flexible Human Activity Sensing. Polymers, 17(16), 2230. https://doi.org/10.3390/polym17162230







